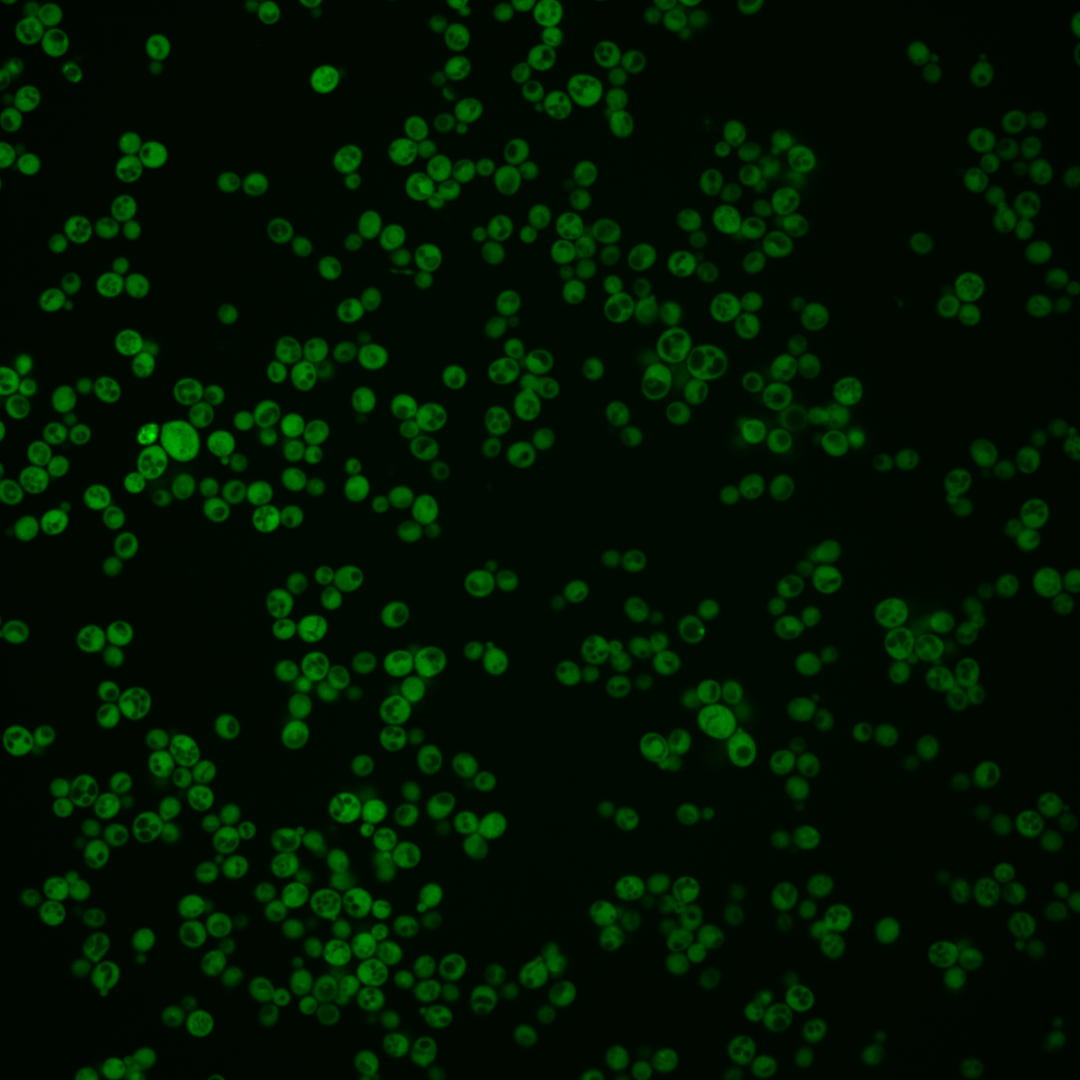
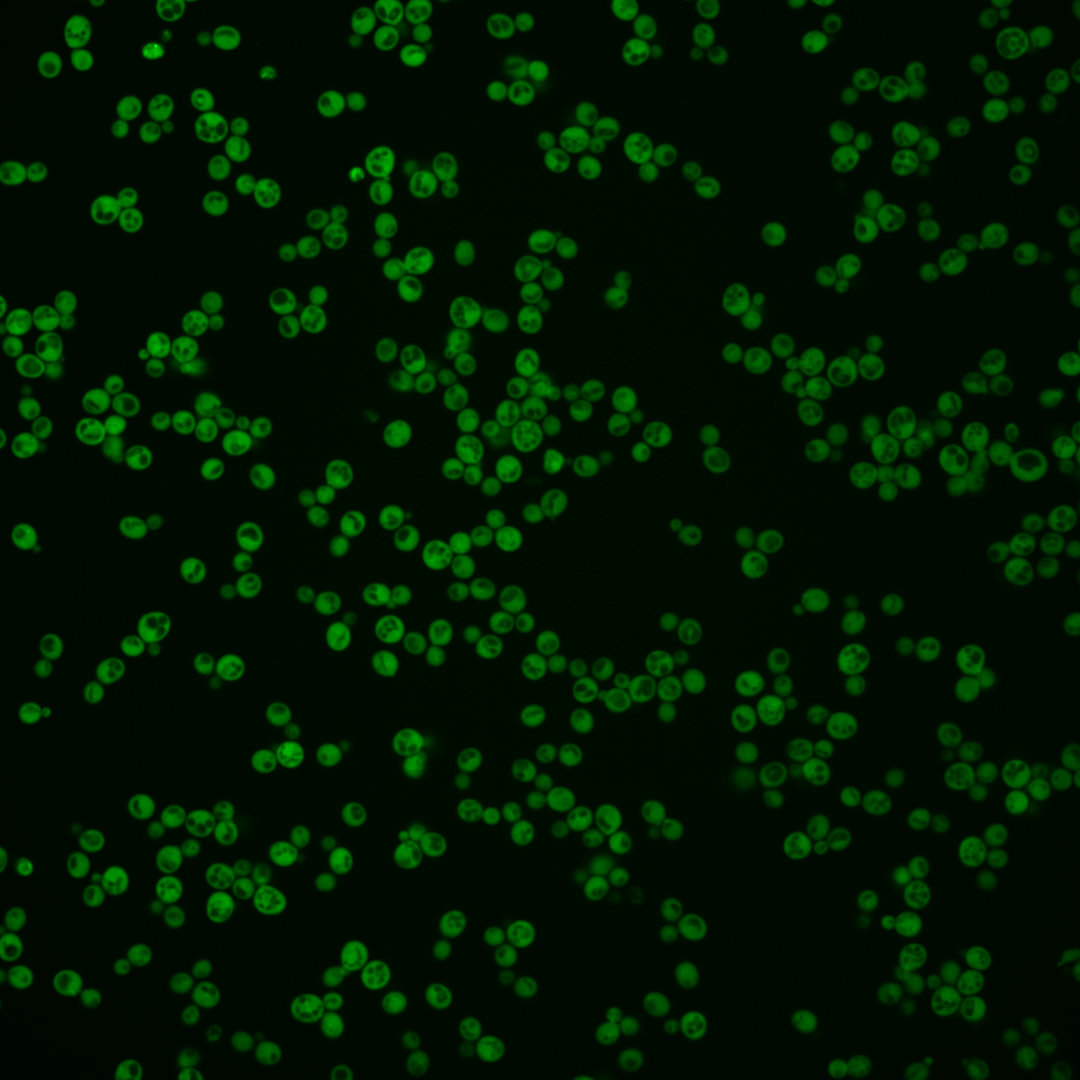
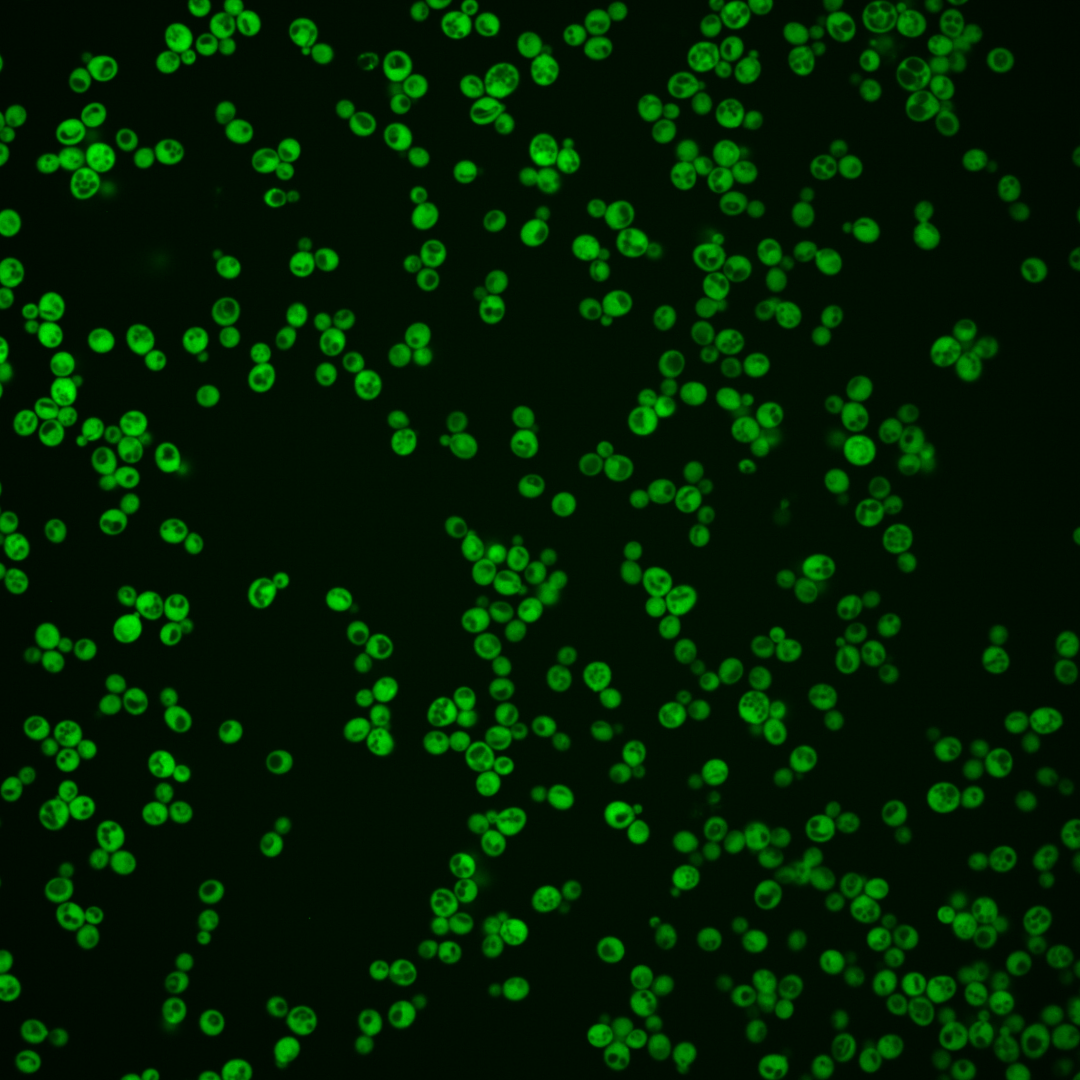
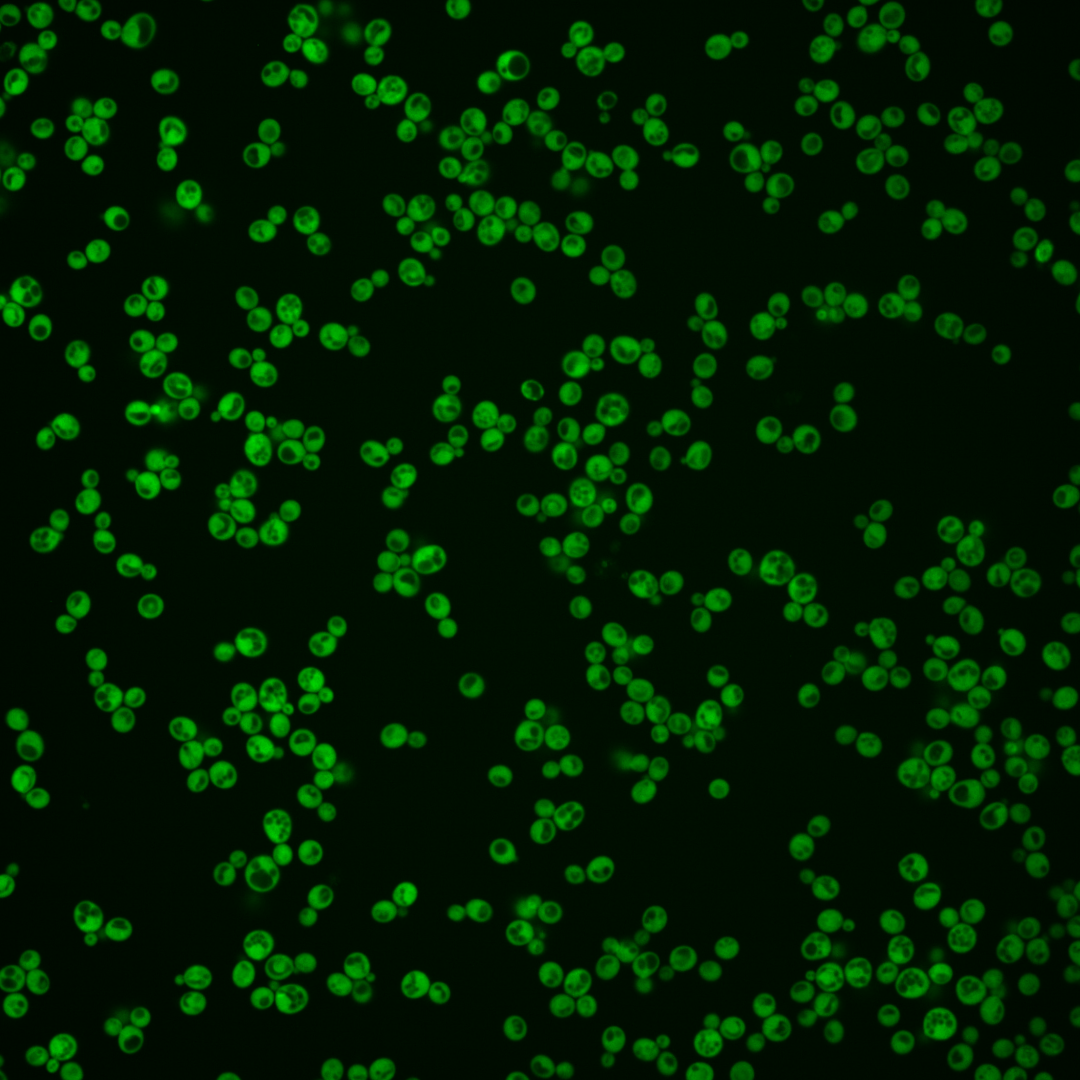
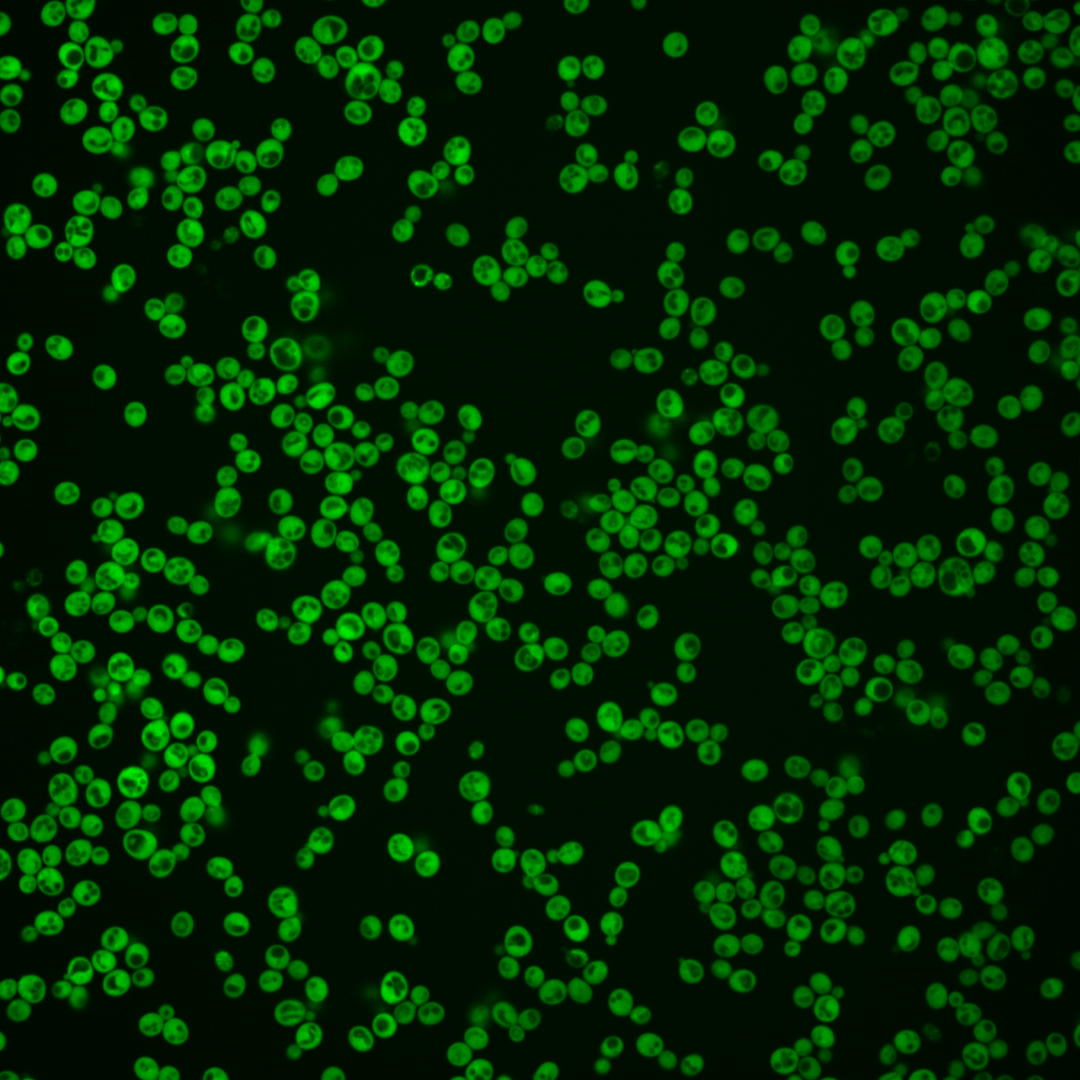
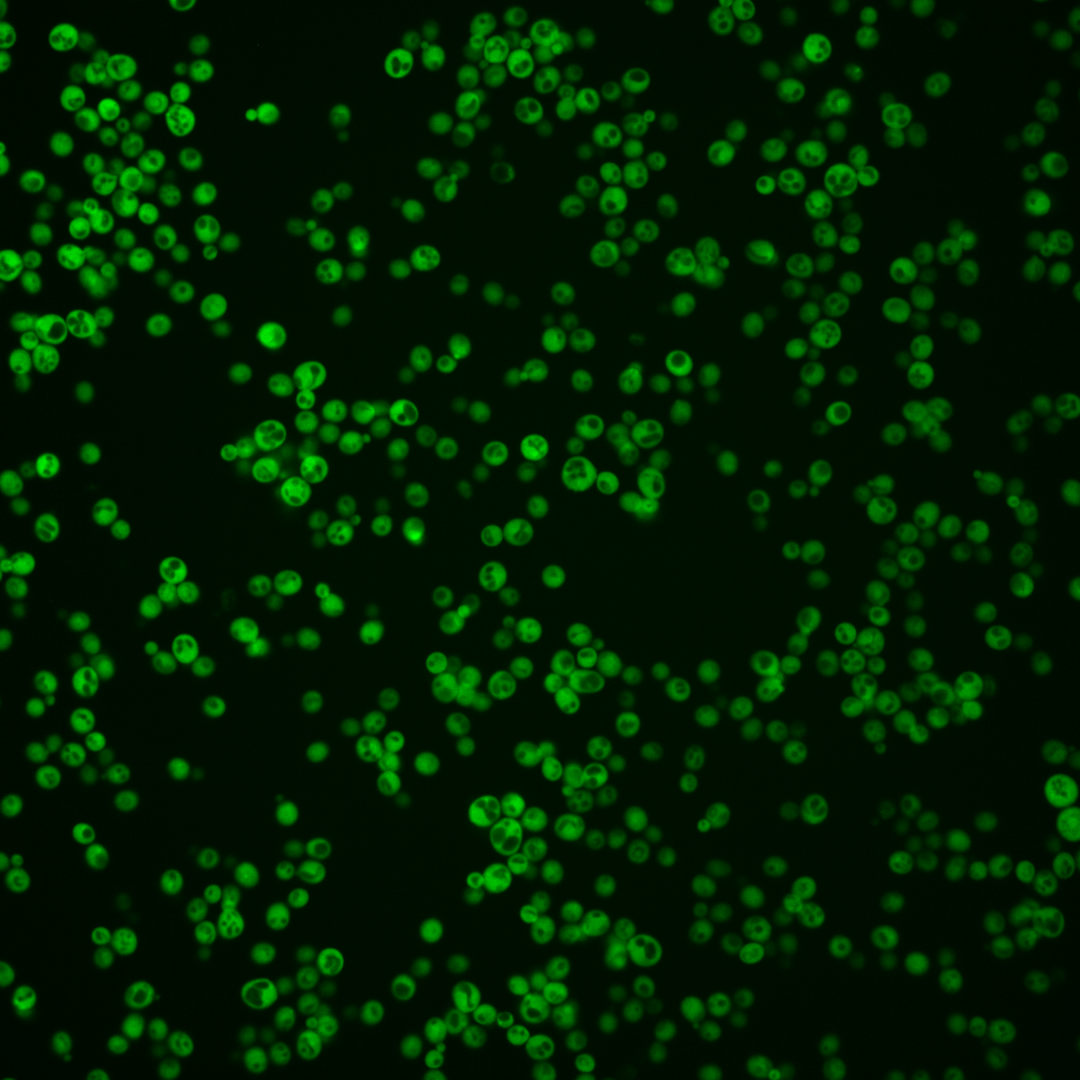
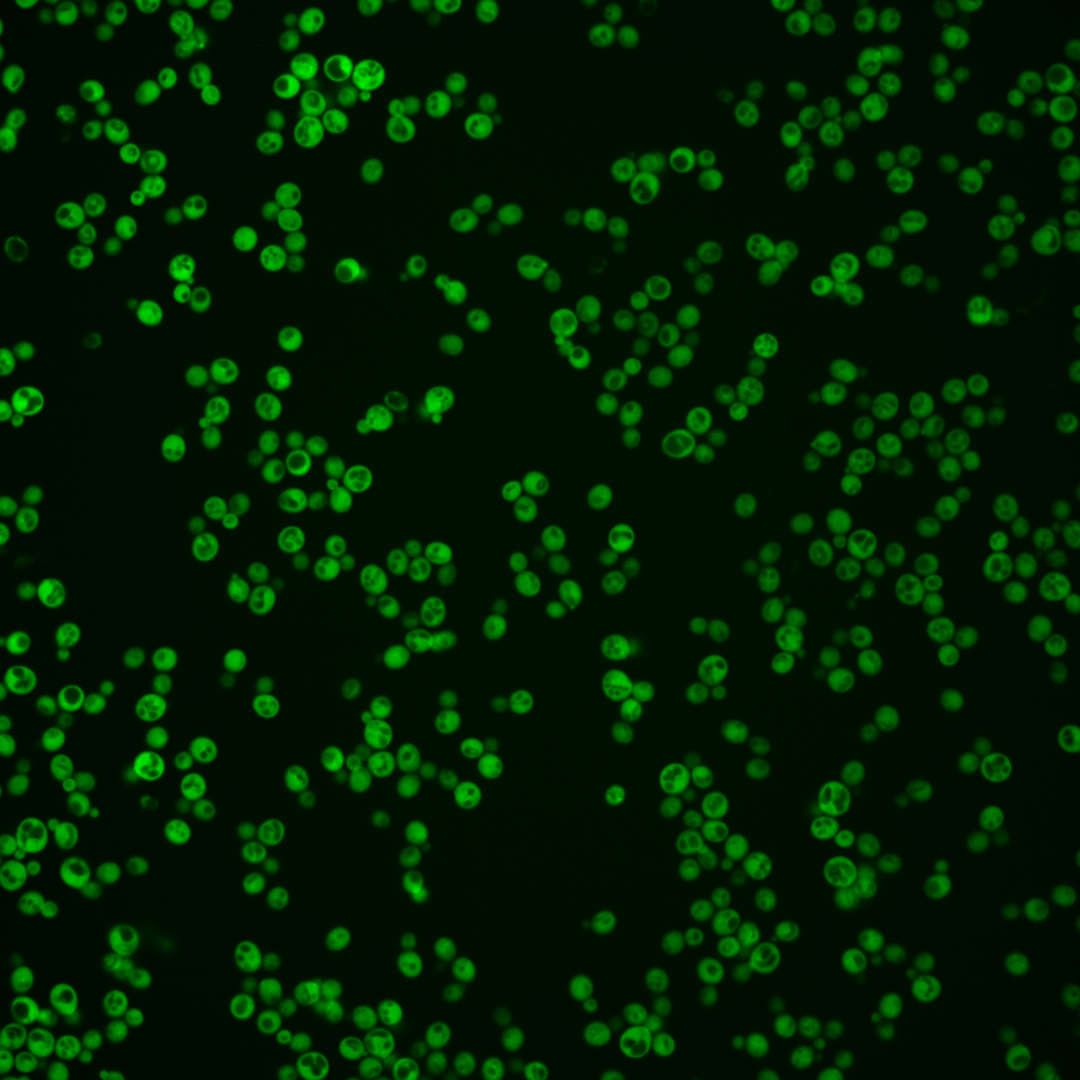

| Standard name | |
|---|---|
| Human Ortholog | |
| Description | Phosphatidylinositol/phosphatidylcholine transfer protein; involved in regulating PtdIns, PtdCho, and ceramide metabolism, products of which regulate intracellular transport and UPR; has a role in localization of lipid raft proteins; functionally homologous to mammalian PITPs; SEC14 has a paralog, YKL091C, that arose from the whole genome duplication |
Micrographs




















































































Sub-cellular Localization
Yeast GFP Assignment
Protein Abundance
Localization Change
External localization resources
| ensLOC | DeepLoc | |||||||||||||||||||||||
|---|---|---|---|---|---|---|---|---|---|---|---|---|---|---|---|---|---|---|---|---|---|---|---|---|
| Localization | WT1 | WT2 | WT3 | RAP60 | RAP140 | RAP220 | RAP300 | RAP380 | RAP460 | RAP540 | RAP620 | RAP700 | HU80 | HU120 | HU160 | rpd3Δ_1 | rpd3Δ_2 | rpd3Δ_3 | WT1 | WT2 | WT3 | AF100 | AF140 | AF180 |
| Cortical Patches | 0 | 0 | 0 | 0 | 0 | 1 | 2 | 5 | 8 | 3 | 6 | 10 | 0 | 0 | 0 | 0 | 0 | 0 | 0 | 0 | 0 | 3 | 0 | 2 |
| Bud | 6 | 0 | 4 | 0 | 9 | 3 | 3 | 8 | 2 | 5 | 4 | 11 | 3 | 2 | 2 | 0 | 0 | 0 | 0 | 1 | 0 | 1 | 3 | 3 |
| Bud Neck | 0 | 0 | 0 | 0 | 0 | 0 | 0 | 0 | 0 | 0 | 0 | 0 | 0 | 0 | 0 | 0 | 0 | 0 | 0 | 0 | 0 | 0 | 0 | 0 |
| Bud Site | 0 | 0 | 0 | 0 | 0 | 0 | 0 | 0 | 0 | 0 | 0 | 0 | 0 | 0 | 0 | 0 | 0 | 0 | – | – | – | – | – | – |
| Cell Periphery | 29 | 6 | 11 | 34 | 33 | 22 | 17 | 17 | 19 | 37 | 34 | 52 | 15 | 13 | 17 | 0 | 6 | 1 | 0 | 0 | 1 | 0 | 0 | 0 |
| Cytoplasm | 329 | 120 | 267 | 276 | 421 | 526 | 528 | 528 | 452 | 501 | 455 | 585 | 292 | 437 | 395 | 110 | 163 | 107 | 337 | 106 | 264 | 272 | 221 | 246 |
| Endoplasmic Reticulum | 0 | 0 | 3 | 5 | 13 | 20 | 69 | 68 | 64 | 86 | 56 | 85 | 4 | 7 | 10 | 6 | 5 | 3 | 1 | 0 | 5 | 4 | 2 | 5 |
| Endosome | 0 | 0 | 1 | 0 | 0 | 0 | 0 | 0 | 0 | 0 | 0 | 0 | 0 | 0 | 0 | 0 | 0 | 0 | 0 | 0 | 1 | 0 | 1 | 0 |
| Golgi | 0 | 0 | 0 | 0 | 0 | 0 | 0 | 0 | 0 | 0 | 0 | 0 | 0 | 0 | 0 | 1 | 0 | 0 | 0 | 0 | 0 | 0 | 0 | 0 |
| Mitochondria | 2 | 0 | 1 | 1 | 1 | 1 | 3 | 1 | 11 | 3 | 21 | 11 | 1 | 0 | 0 | 0 | 0 | 1 | 0 | 0 | 1 | 0 | 0 | 1 |
| Nucleus | 4 | 0 | 0 | 2 | 3 | 3 | 6 | 5 | 4 | 13 | 3 | 5 | 1 | 1 | 0 | 0 | 0 | 0 | 0 | 0 | 0 | 0 | 2 | 0 |
| Nuclear Periphery | 0 | 0 | 0 | 0 | 0 | 0 | 1 | 2 | 0 | 0 | 1 | 1 | 0 | 0 | 0 | 0 | 0 | 0 | 0 | 0 | 0 | 0 | 0 | 0 |
| Nucleolus | 0 | 0 | 0 | 1 | 0 | 0 | 0 | 0 | 1 | 0 | 2 | 0 | 0 | 0 | 0 | 0 | 0 | 0 | 0 | 0 | 0 | 0 | 0 | 0 |
| Peroxisomes | 0 | 0 | 0 | 0 | 0 | 0 | 0 | 0 | 0 | 0 | 0 | 0 | 0 | 0 | 0 | 0 | 0 | 0 | 0 | 0 | 0 | 0 | 0 | 0 |
| SpindlePole | 0 | 0 | 0 | 0 | 0 | 0 | 0 | 0 | 0 | 0 | 0 | 0 | 0 | 0 | 0 | 0 | 0 | 0 | 0 | 0 | 0 | 0 | 0 | 0 |
| Vac/Vac Membrane | 0 | 0 | 0 | 0 | 13 | 0 | 3 | 3 | 6 | 19 | 4 | 7 | 0 | 1 | 1 | 0 | 2 | 2 | 1 | 0 | 2 | 1 | 3 | 4 |
| Unique Cell Count | 335 | 120 | 273 | 287 | 456 | 554 | 609 | 612 | 542 | 629 | 551 | 722 | 299 | 447 | 406 | 112 | 166 | 110 | 344 | 110 | 281 | 290 | 241 | 268 |
| Labelled Cell Count | 370 | 126 | 287 | 319 | 493 | 576 | 632 | 637 | 567 | 667 | 586 | 767 | 316 | 461 | 425 | 117 | 176 | 114 | 344 | 110 | 281 | 290 | 241 | 268 |
Yeast GFP Assignment
Protein Abundance
| Screen | WT1 | WT2 | WT3 | RAP60 | RAP140 | RAP220 | RAP300 | RAP380 | RAP460 | RAP540 | RAP620 | RAP700 | HU80 | HU120 | HU160 | rpd3Δ_1 | rpd3Δ_2 | rpd3Δ_3 | AF100 | AF140 | AF180 |
|---|---|---|---|---|---|---|---|---|---|---|---|---|---|---|---|---|---|---|---|---|---|
| Mean Cell GFP Intensity (1e-4) | 45.9 | 50.3 | 34.3 | 32.2 | 28.4 | 24.4 | 23.7 | 25.4 | 23.7 | 24.2 | 22.8 | 23.2 | 40.0 | 40.3 | 41.5 | 45.8 | 48.3 | 50.1 | 44.0 | 44.1 | 44.3 |
| Std Deviation (1e-4) | 8.1 | 11.1 | 7.4 | 6.6 | 6.6 | 5.0 | 4.7 | 5.6 | 5.2 | 5.2 | 5.0 | 4.7 | 8.3 | 9.2 | 7.8 | 13.5 | 14.1 | 13.1 | 10.9 | 12.1 | 12.3 |
| Intensity Change (Log2) | – | – | – | -0.09 | -0.28 | -0.49 | -0.53 | -0.43 | -0.54 | -0.51 | -0.59 | -0.56 | 0.22 | 0.23 | 0.27 | 0.42 | 0.49 | 0.55 | 0.36 | 0.36 | 0.37 |
Localization Change
| Localization | RAP60 | RAP140 | RAP220 | RAP300 | RAP380 | RAP460 | RAP540 | RAP620 | RAP700 | HU80 | HU120 | HU160 | rpd3Δ_1 | rpd3Δ_2 | rpd3Δ_3 |
|---|---|---|---|---|---|---|---|---|---|---|---|---|---|---|---|
| Cortical Patches | 0 | 0 | 0 | 0 | 0 | 0 | 0 | 0 | 0 | 0 | 0 | 0 | 0 | 0 | 0 |
| Bud | 0 | 0 | 0 | 0 | 0 | 0 | 0 | 0 | 0 | 0 | 0 | 0 | 0 | 0 | 0 |
| Bud Neck | 0 | 0 | 0 | 0 | 0 | 0 | 0 | 0 | 0 | 0 | 0 | 0 | 0 | 0 | 0 |
| Bud Site | 0 | 0 | 0 | 0 | 0 | 0 | 0 | 0 | 0 | 0 | 0 | 0 | 0 | 0 | 0 |
| Cell Periphery | 3.4 | 1.8 | 0 | -1.0 | -1.0 | -0.4 | 1.1 | 1.3 | 1.8 | 0.6 | -0.8 | 0.1 | 0 | -0.2 | 0 |
| Cytoplasm | -1.1 | -3.1 | -1.9 | -5.1 | -5.2 | -6.0 | -7.0 | -6.2 | -6.7 | -0.1 | 0 | -0.4 | 0.3 | 0.3 | -0.3 |
| Endoplasmic Reticulum | 0 | 1.6 | 2.1 | 5.1 | 5.1 | 5.3 | 5.8 | 4.8 | 5.3 | 0 | 0 | 1.3 | 0 | 0 | 0 |
| Endosome | 0 | 0 | 0 | 0 | 0 | 0 | 0 | 0 | 0 | 0 | 0 | 0 | 0 | 0 | 0 |
| Golgi | 0 | 0 | 0 | 0 | 0 | 0 | 0 | 0 | 0 | 0 | 0 | 0 | 0 | 0 | 0 |
| Mitochondria | 0 | 0 | 0 | 0 | 0 | 0 | 0 | 2.9 | 0 | 0 | 0 | 0 | 0 | 0 | 0 |
| Nucleus | 0 | 0 | 0 | 0 | 0 | 0 | 0 | 0 | 0 | 0 | 0 | 0 | 0 | 0 | 0 |
| Nuclear Periphery | 0 | 0 | 0 | 0 | 0 | 0 | 0 | 0 | 0 | 0 | 0 | 0 | 0 | 0 | 0 |
| Nucleolus | 0 | 0 | 0 | 0 | 0 | 0 | 0 | 0 | 0 | 0 | 0 | 0 | 0 | 0 | 0 |
| Peroxisomes | 0 | 0 | 0 | 0 | 0 | 0 | 0 | 0 | 0 | 0 | 0 | 0 | 0 | 0 | 0 |
| SpindlePole | 0 | 0 | 0 | 0 | 0 | 0 | 0 | 0 | 0 | 0 | 0 | 0 | 0 | 0 | 0 |
| Vacuole | 0 | 0 | 0 | 0 | 0 | 0 | 2.9 | 0 | 0 | 0 | 0 | 0 | 0 | 0 | 0 |
External localization resources
Images






























Protein Concentration and Protein Localization Data
| R1 | R2 | R3 | ||||||||||||||||
|---|---|---|---|---|---|---|---|---|---|---|---|---|---|---|---|---|---|---|
| G1 Pre-START | G1 Post-START | S/G2 | Metaphase | Anaphase | Telophase | G1 Pre-START | G1 Post-START | S/G2 | Metaphase | Anaphase | Telophase | G1 Pre-START | G1 Post-START | S/G2 | Metaphase | Anaphase | Telophase | |
| Concentration | 30.8927 | 40.3192 | 36.4718 | 35.3111 | 30.1898 | 38.111 | 35.7403 | 45.1604 | 41.485 | 38.2656 | 38.0118 | 39.2932 | 32.4491 | 41.3635 | 36.7276 | 34.696 | 24.2948 | 38.0533 |
| Actin | 0.0034 | 0.0006 | 0.002 | 0.0124 | 0.0026 | 0.0015 | 0.0033 | 0.0003 | 0.0097 | 0.0027 | 0.0456 | 0.0007 | 0.0027 | 0.0005 | 0.0156 | 0.0007 | 0.0637 | 0.0013 |
| Bud | 0.0007 | 0 | 0.0007 | 0.0005 | 0.0007 | 0.0006 | 0.0002 | 0 | 0.0002 | 0.0035 | 0.0002 | 0.0001 | 0.0002 | 0 | 0.001 | 0.0002 | 0.0015 | 0 |
| Bud Neck | 0.0009 | 0.0005 | 0.0006 | 0.0013 | 0.0013 | 0.0031 | 0.0003 | 0.0003 | 0.0005 | 0.0008 | 0.0007 | 0.0064 | 0.0044 | 0.0005 | 0.0004 | 0.0005 | 0.0021 | 0.0026 |
| Bud Periphery | 0.0006 | 0 | 0.0005 | 0.0008 | 0.0007 | 0.0004 | 0.0002 | 0 | 0.0002 | 0.0049 | 0.0001 | 0.0001 | 0.0002 | 0 | 0.0011 | 0.0004 | 0.0021 | 0 |
| Bud Site | 0.0012 | 0.0003 | 0.0006 | 0.0015 | 0.0008 | 0.0001 | 0.0002 | 0.0001 | 0.0006 | 0.0009 | 0.0005 | 0 | 0.0089 | 0 | 0.005 | 0.0001 | 0.0163 | 0 |
| Cell Periphery | 0.001 | 0.0001 | 0.0006 | 0.0006 | 0.0005 | 0.0003 | 0.0002 | 0.0002 | 0.0002 | 0.0005 | 0.0001 | 0.0001 | 0.0003 | 0 | 0.0001 | 0.0002 | 0.0008 | 0 |
| Cytoplasm | 0.8483 | 0.992 | 0.936 | 0.9187 | 0.8467 | 0.9802 | 0.9177 | 0.9973 | 0.9546 | 0.8955 | 0.9095 | 0.9662 | 0.9143 | 0.9964 | 0.9412 | 0.9265 | 0.6118 | 0.9656 |
| Cytoplasmic Foci | 0.0277 | 0.0005 | 0.0122 | 0.0237 | 0.0341 | 0.0008 | 0.009 | 0.0002 | 0.008 | 0.0129 | 0.0083 | 0.002 | 0.0162 | 0.0001 | 0.0059 | 0.019 | 0.0627 | 0.0018 |
| Eisosomes | 0.0001 | 0 | 0 | 0.0007 | 0 | 0 | 0 | 0 | 0.0001 | 0.0001 | 0.0001 | 0 | 0.0001 | 0 | 0.0001 | 0 | 0.0008 | 0 |
| Endoplasmic Reticulum | 0.0068 | 0.0029 | 0.0049 | 0.0033 | 0.0046 | 0.0073 | 0.0059 | 0.0005 | 0.0014 | 0.0019 | 0.0076 | 0.0049 | 0.0024 | 0.0008 | 0.0025 | 0.0115 | 0.0024 | 0.0043 |
| Endosome | 0.0225 | 0.0001 | 0.0073 | 0.0055 | 0.028 | 0.0002 | 0.013 | 0 | 0.0024 | 0.008 | 0.0103 | 0.001 | 0.0078 | 0 | 0.0045 | 0.0044 | 0.0412 | 0.0002 |
| Golgi | 0.0033 | 0 | 0.002 | 0.0045 | 0.0185 | 0.0001 | 0.0023 | 0 | 0.0019 | 0.0008 | 0.0017 | 0.0001 | 0.0013 | 0 | 0.0021 | 0.0006 | 0.0307 | 0.0003 |
| Lipid Particles | 0.0124 | 0.0001 | 0.0073 | 0.0107 | 0.0127 | 0.0001 | 0.0041 | 0 | 0.008 | 0.0041 | 0.0062 | 0.0003 | 0.0097 | 0 | 0.0024 | 0.0108 | 0.0716 | 0.0049 |
| Mitochondria | 0.0119 | 0 | 0.0024 | 0.0057 | 0.0085 | 0.0002 | 0.0026 | 0 | 0.0027 | 0.0175 | 0.0011 | 0.0089 | 0.0073 | 0 | 0.0053 | 0.0025 | 0.0375 | 0.0053 |
| None | 0.0052 | 0.0002 | 0.0067 | 0.0026 | 0.0043 | 0.0003 | 0.0049 | 0.0001 | 0.0016 | 0.004 | 0.0014 | 0.0012 | 0.0045 | 0.0001 | 0.0036 | 0.0031 | 0.0035 | 0.0001 |
| Nuclear Periphery | 0.0063 | 0.0007 | 0.0017 | 0.0014 | 0.0036 | 0.001 | 0.0111 | 0.0002 | 0.0007 | 0.009 | 0.0024 | 0.0005 | 0.0017 | 0.0004 | 0.0029 | 0.0074 | 0.0087 | 0.0009 |
| Nucleolus | 0.0034 | 0 | 0.0008 | 0.0003 | 0.0007 | 0.0001 | 0.0002 | 0 | 0.0001 | 0.0022 | 0 | 0.0017 | 0.0005 | 0 | 0.0002 | 0.0005 | 0.001 | 0 |
| Nucleus | 0.0139 | 0.0017 | 0.0029 | 0.0024 | 0.0038 | 0.0031 | 0.0052 | 0.0007 | 0.0011 | 0.0038 | 0.0014 | 0.0024 | 0.003 | 0.001 | 0.0022 | 0.0038 | 0.0021 | 0.0027 |
| Peroxisomes | 0.002 | 0 | 0.0023 | 0.0015 | 0.0056 | 0 | 0.0064 | 0 | 0.0036 | 0.0009 | 0.001 | 0.0002 | 0.009 | 0 | 0.0006 | 0.0008 | 0.0273 | 0.0095 |
| Punctate Nuclear | 0.0114 | 0.0001 | 0.0024 | 0.0008 | 0.001 | 0.0002 | 0.0061 | 0 | 0.0008 | 0.0061 | 0.0008 | 0.0005 | 0.0033 | 0 | 0.0019 | 0.0017 | 0.0053 | 0.0001 |
| Vacuole | 0.0134 | 0.0001 | 0.0049 | 0.001 | 0.0158 | 0.0003 | 0.0045 | 0 | 0.0013 | 0.0125 | 0.0007 | 0.0022 | 0.0016 | 0 | 0.0009 | 0.0033 | 0.0045 | 0.0001 |
| Vacuole Periphery | 0.0036 | 0 | 0.0011 | 0.0003 | 0.0055 | 0.0001 | 0.0026 | 0 | 0.0002 | 0.0076 | 0.0004 | 0.0005 | 0.0006 | 0 | 0.0006 | 0.002 | 0.0022 | 0 |
Sequencing Data
| R1 | R2 | |||||||||
|---|---|---|---|---|---|---|---|---|---|---|
| G1 Post-START | S/G2 | Metaphase | Anaphase | Telophase | G1 Post-START | S/G2 | Metaphase | Anaphase | Telophase | |
| Gene Expression | 268.9171 | 293.2178 | 222.3799 | 192.7911 | 229.836 | 278.4102 | 235.7063 | 179.1326 | 174.9152 | 214.9034 |
| Translational Efficiency | 2.0614 | 1.9452 | 1.692 | 2.0608 | 1.9863 | 2.0086 | 1.8868 | 2.2033 | 1.8108 | 1.9534 |
Hit Data
| Dataset | Hit |
|---|---|
| Protein Concentration | ✔ |
| Protein Localization | ✘ |
| Gene Expression | ✔ |
| Translational Efficiency | ✘ |
Endocytosis
| Temp | Actin Patch (Sac6-tdTomato) | Cortical Patch (Sla1-GFP) | Late Endosome (Snf7-GFP) | Vacuole (Vph1-GFP) |
|---|---|---|---|---|
| 37℃ | ||||
| RT |
Cell Cycle Omics
CYCLoPs (Sec14-GFP)
| Gene / Allele | Actin Patch (Sac6-tdTomato) | Cortical Patch (Sla1-GFP) | Late Endosome (Snf7-GFP) | Vacuole (Sac6-tdTomato) |
|---|
| Gene | Images |
|---|
| Gene | Images |
|---|
Images are not yet available
Images are not yet available